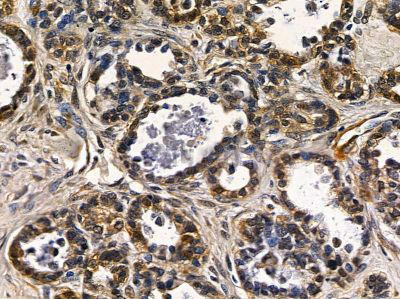
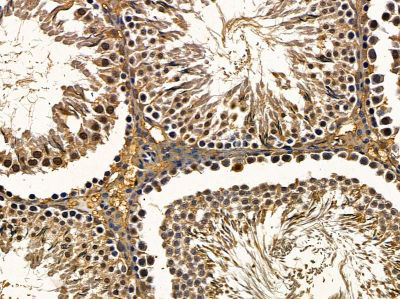

- 网站首页
- 产品中心
-
实验服务
- 常规实验服务
- 免疫组化&HE染色
- WB蛋白免疫印迹
- 荧光定量qPCR
- 特殊病理染色
- 流式细胞术
- 细胞培养&转染&感染
- CCK8检测
- Tunel&Annexin V凋亡检测
- 细胞生物学实验
- 外泌体分离&鉴定及检测
- 小RNA&LncRNA&CircRNA
- 基因编辑&质粒&病毒构建
- 干细胞实验
- 类器官实验
- 整体实验服务
- 实验方案设计服务
- 心血管系统实验服务
- 神经系统实验服务
- 呼吸系统实验服务
- 内分泌系统实验服务
- 消化系统实验服务
- 泌尿&生殖系统实验服务
- 骨及关节实验服务
- 感官系统实验服务
- 免疫系统实验服务
- 皮肤疾病实验服务
- 肿瘤疾病实验服务
- 综合疾病实验服务
- 资源中心
- 行业资讯
- 关于公司
- 联系我们
-
400-698-4168




 产品订购:
产品订购:
 渠道电话:
渠道电话: